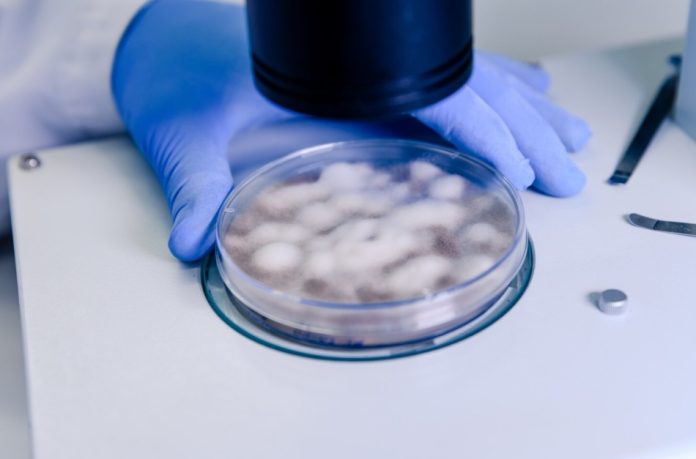
Lupin Diagnostics

Kidneys work quietly, filtering waste, balancing electrolytes, and keeping fluid levels steady. When diabetes or high blood pressure (BP) enters the picture, those filters shoulder an extra load. Regular checks with a Renal Function Test (RFT) or KFT test help you see what’s happening behind the scenes, so conversations with your clinician are based on clear, current information.
Table of Contents
Why Diabetes and High BP Put Kidneys Under Pressure?
With diabetes, fluctuations in blood sugar can nudge the delicate filters to work harder than usual. High BP can have a similar effect by increasing pressure in the tiny vessels that support filtration. Neither change is dramatic from one day to the next, which is why periodic testing is helpful. It highlights subtle shifts early, well before you feel anything, and gives your clinician a fuller picture when planning your next steps.
Think of it like maintaining a vehicle you rely on every day. You may not hear a strange sound or see a warning light, yet a routine service still picks up early signs of wear. Kidney monitoring plays a similar preventive role.
What an RFT/KFT Usually Covers
Different laboratories may label the panel slightly differently. However, most KFT/RFT panels aim to show how efficiently your kidneys are filtering and whether your fluid-electrolyte balance appears stable. Key markers typically include:
- Serum Creatinine: A practical indicator of filtration efficiency that your clinician interprets alongside history, hydration, body composition, and medicines.
- Estimated GFR (eGFR): A calculated estimate of filtration. Your clinician will focus on trends rather than a single value.
- Blood Urea: Reflects protein breakdown and filtration dynamics; can be influenced by diet and hydration.
- Uric Acid: Considered with the rest of the report to understand how your body handles certain waste products.
- Electrolytes (Sodium, Potassium, Chloride, Bicarbonate): Offer a snapshot of fluid and acid–base balance, which may be relevant if you live with high BP or take certain medicines.
- Urine Albumin/Protein (Sometimes as an Albumin–Creatinine Ratio): Even small amounts may be an early clue that the filters are under strain.
Individually, none of these numbers tells the whole story; together, and in context, they guide a well-rounded discussion with your clinician.
Who Should Consider Regular Testing
Below are the people who should consider this test from time to time:
- People Living With Diabetes: Early changes may appear in the report before symptoms do.
- People With High BP: Monitoring shows how your current plan is helping protect your kidneys.
- Those on Long-Term Medicines With Renal Considerations: Your doctor can advise a sensible testing interval.
- Anyone Advised by a Clinician: Prior history or symptoms may warrant periodic checks.
How to Read Your Report Calmly
It’s natural to look for markers labelled high or low. A more grounded approach is to focus on patterns and context:
- Prioritise Trends Over Single Values: Hydration, a hard workout, or recent diet changes can nudge a one-off result.
- Consider the Whole Panel: eGFR, creatinine, and urine findings complement each other.
- Match Results to Real Life: Share any recent changes, new medicines, travel, dehydration, or illness, so your clinician can interpret the panel accurately.
- Avoid Self-Adjusting Medicines: Use the report to inform a conversation, not to make unsupervised changes.
Preparing for Your Test Day
Here are the steps that you have to follow before coming on the test day:
- Hydration: Arrive normally hydrated unless your clinician or the lab provides different instructions.
- Fasting: Follow the specific guidance on your booking slip; some panels do not need fasting.
- Medicines and Supplements: Tell the lab and your clinician what you’re taking. Any temporary pauses should only be on your clinician’s advice.
- Consistency: If repeat tests are planned, try to test at similar times and under similar conditions so comparisons are clearer.
Booking Options Many Indians Prefer
Life is busy, and convenience makes follow-through more likely. Many people choose to book KFT test online. When arranging a slot, think about:
- Home Collection or Centre Visit: Choose the route that helps you stay consistent with monitoring.
- Turnaround and Access: If you’re meeting your clinician soon after, check typical report timelines so you can carry results.
- Clarity on Inclusions: Confirm whether urine protein or extended electrolytes are bundled or listed separately.
Lupin Diagnostics is a diagnostic centre where individuals commonly schedule blood tests, including RFT/KFT. If you value a streamlined digital process, you can explore booking options with Lupin Diagnostics to organise your reports neatly and keep your monitoring on track.
Keeping Kidney Health on Your Checklist
For those living with diabetes or high BP, kidney checks sit alongside home BP logs, blood sugar monitoring, eye and foot health reviews, nutrition, hydration, movement, and sleep. The point is not to chase numbers but to stay informed and act thoughtfully.
- Schedule Sensibly: Set reminders for your next KFT/RFT as advised by your clinician.
- Store Reports Together: Digital folders or printed files help track trends without stress.
- Arrive Prepared: Bring your medicine list and any recent readings so your clinician has the full context.
Conclusion
Diabetes and high BP place stress on the kidneys. A periodic Renal Function Test or KFT test turns that hidden story into useful information, and that information powers practical, clinician-led decisions. If convenience helps you stay consistent, you can book Renal Function Test online through reputable providers and carry the reports to your appointments.
Lupin Diagnostics can be part of that plan, helping you organise results without implying treatment or confirming any diagnosis. The goal is simple: check, understand, and act with professional guidance, calmly and on time.
Disclaimer: This article is for general awareness only. It does not provide medical advice and should not be used to diagnose any condition or decide on treatment. Always consult a qualified healthcare professional for personal guidance. Your clinician should interpret laboratory test results and reference intervals.